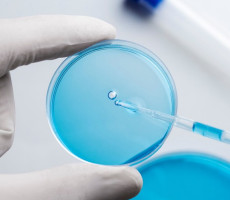

Ջրի անալիզ
Ամոնիակ, ամոնիումի իոն, ջրածնի ինդեքս (pH) հիդրոկարբոնատներ, ընդհանուր երկաթ, ընդհանուր կարծրություն, բույրով, պղտորություն, նիտրատներ, պերմանգանատի օքսիդացում, բուրմունք կետերով, սուլֆատներ, ֆտորիդներ, քլորիդներ, գույնը աստիճաններով, ընդհանուր ալկալայնություն:

Ամոնիակ, ամոնիումի իոն, ջրածնի ինդեքս (pH) հիդրոկարբոնատներ, ընդհանուր երկաթ, ընդհանուր կարծրություն, բույրով, կալիում, կալցիում, մագնեզիում, պղտորություն, նատրիում, նավթամթերք, նիտրատներ, նիտրիտներ, ընդհանուր հանքայնացում (չոր պարունակություն), պերմանգանատի օքսիդացում, համ միավորներով, սուլֆատներ, ֆտորիդներ, քլորիդներ, գույնը աստիճաններով, ընդհանուր ալկալայնություն:

Ալյումին, ամոնիումի իոն, ջրածնի արժեք (pH), հիդրոկարբոնատներ, երկաթ
ընդհանուր, ընդհանուր կարծրություն, բուրմունք կետերում, կադմիում, կալիում, կալցիում, մագնեզիում, մանգան, պղինձ, մոլիբդեն, պղտորություն, մկնդեղ,
Նատրիում, նավթամթերք, նիկել, նիտրատներ, նիտրիտներ, ընդհանուր հանքայնացում (չոր մնացորդ), պերմանգանատի օքսիդացում,
Համային կետեր, սնդիկ, կապար, սելեն, ջրածնի սուլֆիդ, սուլֆատներ, ֆտորիդներ, քլորիդներ, գույնի աստիճաններ, ալկալիություն
գեներալ

Ընդհանրացված կոլիֆորմ բակտերիաներ, մանրէների ընդհանուր քանակ,
Ջերմակայուն կոլիֆորմ բակտերիաներ

Ջրածնի ինդեքս (pH), Նավթամթերք, Կախված նյութեր մգ/դմ3,
BOD 5, COD, ընդհանուր ազոտ, ընդհանուր ֆոսֆոր, քլոր և քլորամիններ, ալյումին, երկաթ, կադմիում, մանգան, COD:BOD հարաբերակցությունը 5,
Ֆենոլներ (ընդհանուր), պղինձ, մկնդեղ, նիկել, սնդիկ, սուլֆիդներ և ջրածնի սուլֆիդ, ընդհանուր քրոմ, վեցավալենտ քրոմ, ճարպեր, ացետոն,
տոլուոլ, մեթանոլ, բութանոլ-1, պրոպանոլ-1, ոչ իոնային մակերևութային ակտիվ նյութեր, անիոնային մակերևութային ակտիվ նյութեր, բութանոլ-2, կապար, ցինկ, պրոպանոլ-2, էթանոլ,
Սուլֆատներ, քլորիդներ

ՀՀ, ք․ Երևան, սբ. Արմենակյան, 129/5 հասցեն:
+374 77 325551
info@analyticlab.am
ՀՎՀՀ 01054039
